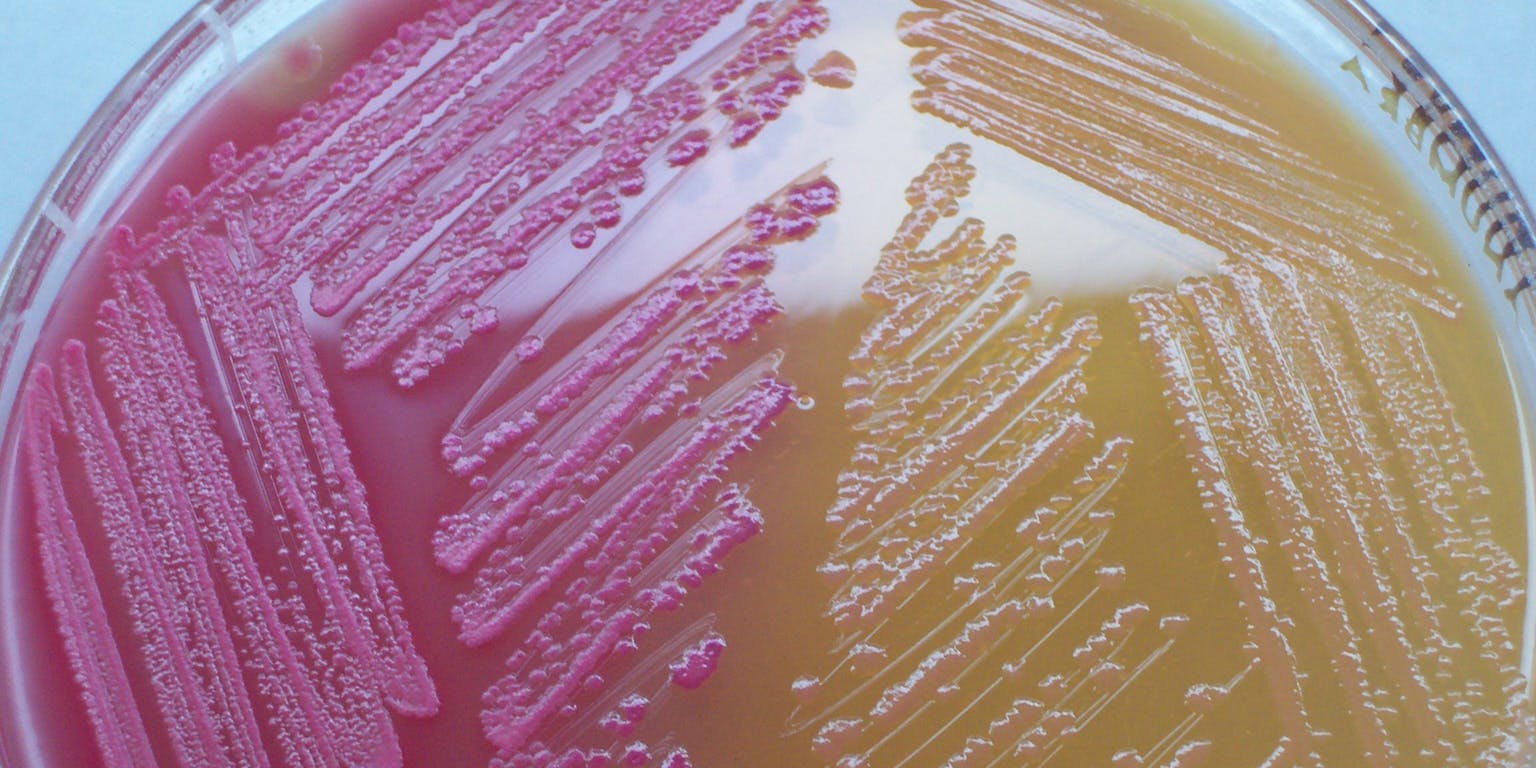
Een close-up van micro organismen met een roze en gele kleur.

Kun je een bacterie zo aanpassen dat hij precies dàt gaat doen wat jij van hem wilt? Die vraag is de inzet van het IGEM-fonds. In een jaarlijks terugkerende competitie nemen studententeams het tegen elkaar op om de best uitgedachte toepassing te presenteren op een congres, dat nu plaatsvindt. We spraken vooraf met Marjolein ten Dam en Khadija Ahmiane van team Utrecht.
Terwijl eerder dit jaar het Europese Hof van Justitie nog viel over een versoepeling van regels voor het genetisch modificeren van planten, staat deze week in Boston een vraag centraal die daar haaks op lijkt te staan: wie modificeert het best? Het ‘slachtoffer’ van modificatie is de E. Coli-bacterie.

E. coli komt voor in je darmen, maar is ook veelvuldig wetenschappelijk onderzocht.
Wetenschap24Dat is niet toevallig: van E. Coli weten we bijna alles. En het is ook de bacterie die al 35 jaar in gemodificeerde vorm insuline maakt voor suikerpatiënten. En dus speelt E. Coli bij IGEM de hoofdrol. Het IGEM-fonds (IGEM staat voor International Genetically Engineered Machine) organiseert elk jaar een competitie voor studenten om in teams tot nieuwe toepassingen te komen van gemodificeerde E. Coli’s.
In 2003 ontstond op het Massachusetts Institute of Technology (MIT) het idee om studenten te laten kennismaken met het genetisch aanpassen van levende organismen. Dat had knipperende bacteriën tot gevolg. Een jaar later was er een kleine competitie met vijf teams. Inmiddels zijn er meer dan driehonderd teams en vijfduizend deelnemers. De toepassingen zijn legio: team Eindhoven werkte de afgelopen maanden aan een bacteriële rookmelder, team Rotterdam aan een desinfecterende wondgel.
Medicijnen
Marjolein ten Dam en Khadija Ahmiane waren in de eerste plaats gedreven door interesse. Marjolein ten Dam: “Je hebt een halfjaar voor zo’n project, en het is een unieke ervaring. Ik ben zelf medisch bioloog, maar je zit ineens met een multidisciplinair team van studenten om de tafel en je werkt samen aan een probleem. Dat leer je heel veel van, en het is ook nog eens leuk.”
Het probleem waar Team Utrecht het hoofd over heeft gebogen is de vervuiling van rioolwater door medicijnen. Het is voor waterzuiveraars kostbaar om op allerlei verschillende vormen van vervuiling te scannen, omdat er erg veel verschillende soorten medicijnen zijn. Antidepressiva bijvoorbeeld zijn lastig op te sporen en blijven ook in water actief. En het is niet de bedoeling dat mensen of dieren ze onbedoeld binnen krijgen.
Verkleurend water
Stel nu, dacht Team Utrecht, dat we een bacterie kunnen uitrusten met sensoren voor de meest voorkomende vervuiling, of de meest schadelijke, en we zorgen ervoor dat je aan de bacterie eenvoudig kunt zien of die iets signaleert, dan kun je met een reageerbuisje bacteriën je afvalwater eenvoudig screenen op de aanwezigheid van medicijnen. “Dat is veel goedkoper dan dat je tien verschillende chemische tests moet doen”, meent teamlid Khadija Ahmiane.
In 2,5 minuten leggen de studenten uit hoe het werkt, in het Engels.
De uitdaging was om een receptor te maken – dat is een molecuul dat door het celmembraan steekt – die aan de buitenkant van de cel zou reageren op de aanwezigheid van vervuiling, en dan aan de binnenkant van de cel een stof zou afgeven die je makkelijk kon zien. Een paar vergaderingen verder leek het erop dat een reactie tussen twee proteïnes als mogelijk signaal kon dienen: luciferase, dat blauw licht verspreidt en Yellow fluorescent protein (YFP), dat geel licht verspreid, maar dan alleen als hij een verbinding maakt met luciferase.
Het idee was om een derde proteïne die E. Coli van nature al heeft aan de receptor vast te maken die luciferase en YFP uit elkaar drukt. In schoon water is de E. Coli daardoor geel, terwijl in verontreinigd water de derde proteïne ervoor zorgt dat YFP loskomt van luciferase. Verontreiniging zie je dan doordat het verontreinigde water verkleurt.
Kill switch
In berichtgeving over genetische modificatie-technieken, zoals CRISPR-Cas lijkt het net of het naar believen in elkaar zetten op een achternamiddagje voor elkaar is, maar Marjolein en Khadija hebben een andere ervaring. Marjolein: “Tachtig procent van wat je in het lab doet, werkt niet. Het is trial and error. Meestal leidt het ertoe dat al je bacteriën binnen een experiment dood zijn, en dan kun je opnieuw beginnen. Dat was voor mij wel een eye-opener: het is ontzettend moeilijk om het echt werkend te krijgen.”
Makkelijk was het plan sowieso niet. Ga maar na: de genetisch gemanipuleerde E. Coli van Team Utrecht moest twee extra proteïnes aanmaken én een receptor die verschillende soorten verontreiniging kon bespeuren. Dat vereist nogal wat gesleutel aan het erfelijk materiaal van E. Coli. Khadija: “We hebben dankbaar gebruik gemaakt van de kennis van IGEM-teams van eerdere competities. Dat moedigt IGEM ook erg aan, trouwens, want anders zit je voor alles opnieuw het wiel uit te vinden. IGEM heeft inmiddels een aardige bibliotheek met ‘biobricks’ opgebouwd; bouwstenen die indien nodig in E. Coli kunnen worden ingebouwd.”
Een week voor het vertrek naar de presentatie in Boston had het team een bacterielijn die van kleur kon verschieten en een lijn die kon signaleren of er verontreiniging in het water zat. Het bij elkaar brengen van die eigenschappen was een volgende uitdaging.
Een apart probleem daarbij vormt voor elk IGEM-team het inbouwen van een zogenoemde “kill switch”. Het is niet de bedoeling dat de gemodificeerde E. Coli schadelijk kan zijn. Khadija: “Bij onze toepassing zou de bacterie het wateranalysecentrum in principe niet uit komen, maar daar kun je nooit helemaal van op aan. Idealiter wil je dat de E. Coli die je ontwerpt alleen in het lab kan overleven. Je maakt hem afhankelijk van een bepaalde stof die buiten het lab niet voorhanden is. Maar het is een hele klus om ook die eigenschap nog toe te voegen.”
Urgentie
“Het wordt nachtwerk, zeker nu de deadline nadert”, zegt Marjolein. “Iedereen gaat een stap harder. Maar het is enorm leerzaam.” Voor de conferentie maakt het ook niet uit of een toepassing echt helemaal werkt. Originaliteit en de urgentie van het probleem dat wordt opgelost spelen ook een belangrijke rol.
De conferentie in Boston duurt tot 28 oktober. Dan is bekend of een van de Nederlandse teams een prijs heeft gewonnen.